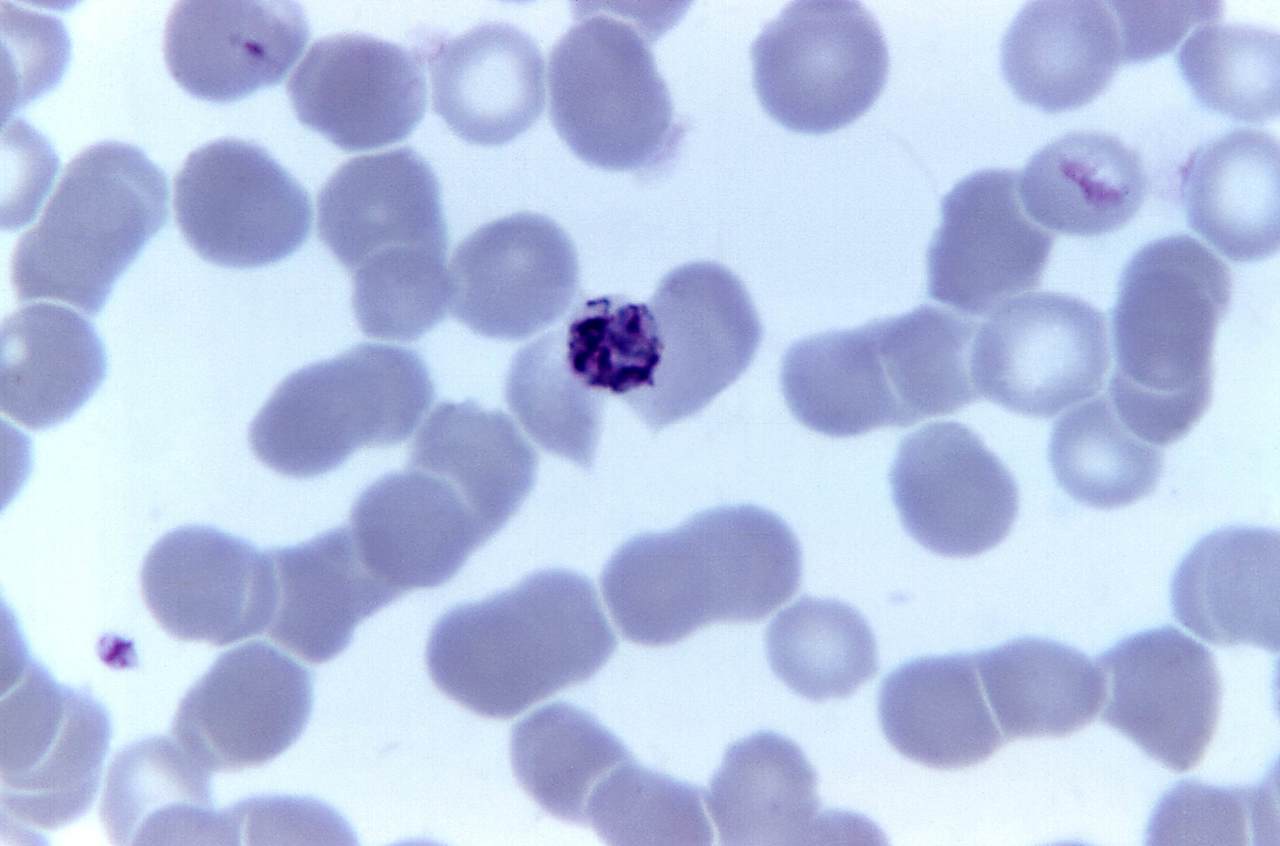

Multiplikation-division
Skolform
Grundskola
Årskurs
F
Prästängsskolan · Lunds för- och grundskolor
3 maj 2019
Grundskola
·
Årskurs F
·
Prästängsskolan, Lunds för- och grundskolor
·
3 maj 2019
Vi kommer att arbeta med multiplikation med 10, 100 och 1000 samt division med dessa tal. Samband mellan multiplikation och division kommer att beröras . Kort division, division med rest, multiplikation med uppställning är några av områden vi kommer att jobba med.
Matriser i planeringen
Innehåller inga matriser
Uppgifter
Innehåller inga uppgifter